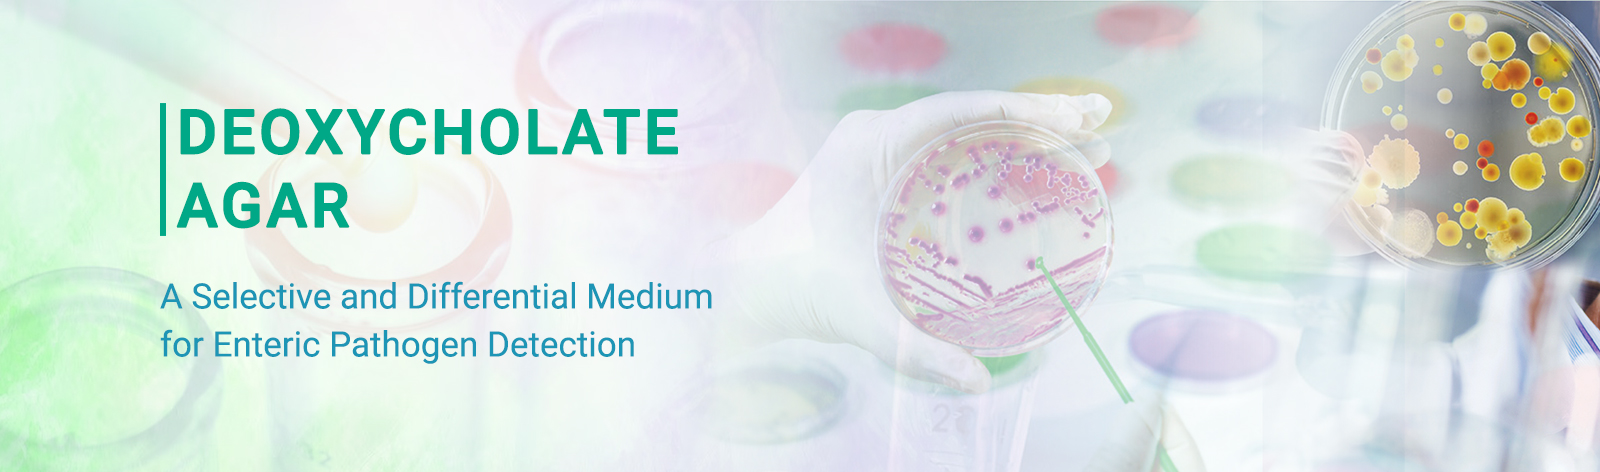

Deoxycholate Agar: A Selective and Differential Medium for Enteric Pathogen Detection
Deoxycholate Agar is a selective and differential culture medium commonly used in microbiological laboratories for the isolation and differentiation of enteric Gram-negative bacteria, particularly members of the family Enterobacteriaceae, with specific emphasis on the detection of Salmonella and Shigella species. The medium has played a significant role in clinical, pharmaceutical, food, and water microbiology, where reliable detection of intestinal pathogens is essential for public health and quality control.
1. Historical Background and Discovery:
The development of selective media for enteric pathogens emerged in the early 20th century, driven by the need to identify causative agents of gastrointestinal diseases such as typhoid fever, dysentery, and foodborne infections. Deoxycholate Agar is historically linked to the pioneering work of Alexander H. Hynes, who introduced bile salt–based selective media in the 1930s and 1940s. His research focused on exploiting the inhibitory effect of bile salts on Gram-positive organisms while allowing the growth of intestinal Gram-negative bacilli.
The inclusion of sodium deoxycholate, a secondary bile salt, constituted a significant advancement over earlier bile salt–based formulations. Sodium deoxycholate demonstrated enhanced selective inhibitory activity against Gram-positive organisms while exhibiting reduced inhibitory effects on susceptible enteric Gram-negative bacteria, thereby improving the recovery of target pathogens. With continued validation and widespread use, Deoxycholate Agar became established as a standardized selective and differential medium and was subsequently incorporated into clinical and food microbiology compendia. Commercially prepared formulations, such as Deoxycholate Agar (M030), were developed to ensure batch-to-batch consistency, analytical reproducibility, and compliance with regulatory quality requirements.
2. Principle of the Medium:
Deoxycholate Agar operates on the principles of selective inhibition and differential carbohydrate fermentation. Selectivity in Deoxycholate Agar is achieved primarily through sodium deoxycholate, in combination with sodium citrate, inhibit the growth of Gram-positive organisms by disrupting cytoplasmic membrane integrity and altering cellular permeability. In contrast, most Gram-negative enteric bacteria exhibit inherent tolerance to bile salts, permitting their growth on the medium.
Differentiation is based on the capacity of microorganisms to ferment lactose. Lactose-fermenting organisms, including Escherichia coli and Klebsiella species, metabolize lactose with the production of acidic end products, resulting in a localized decrease in pH. This acidification induces a color change in the incorporated pH indicator, enabling neutralized visual distinction from non-lactose-fermenting organisms such as Salmonella and Shigella species, which do not produce acid from lactose under the specified incubation conditions.
Consequently, Deoxycholate Agar facilitates the selective isolation of enteric Gram-negative bacteria while simultaneously providing differential identification based on lactose fermentation patterns.
3. Purpose and Rationale for Development:
The primary objective of developing Deoxycholate Agar was to enable the selective isolation of intestinal pathogens from specimens with high levels of commensal microbial flora, including fecal material, sewage, and food matrices. Conventional non-selective media were frequently compromised by overgrowth of Gram-positive organisms or rapidly lactose-fermenting coliforms, which obscured the detection of clinically relevant enteric pathogens.
The inclusion of sodium deoxycholate confers selective inhibition of competing Gram-positive bacteria, while lactose serves as a differential substrate enabling discrimination between lactose-fermenting and non-lactose-fermenting enteric organisms. Collectively, these attributes rendered Deoxycholate Agar a valuable medium for epidemiological surveillance, outbreak investigations, and routine microbiological analysis of enteric pathogens.
4. Composition of HiMedia’s Deoxycholate Agar (M030):
The formulation of HiMedia’s Deoxycholate Agar (M030) is designed to support microbial growth while providing selective and differential properties. Peptone supply essential nitrogenous nutrients, amino acids, vitamins, and growth factors required for bacterial proliferation. Lactose functions as the fermentable carbohydrate, enabling differentiation of lactose-fermenting organisms from non-fermenters. Sodium deoxycholate serves as the selective agent by inhibiting the growth of Gram-positive bacteria and partially suppressing the swarming of Proteus species. Neutral red is incorporated as a pH indicator, yielding red to pink colony coloration in lactose-fermenting organisms as a result of acid production. Sodium chloride maintains osmotic equilibrium within the medium, while agar provides a solid matrix for colony development. The final pH of the medium is adjusted to near neutrality, typically 7.3 ± 0.2, to facilitate optimal growth and recovery of enteric bacteria. Under these conditions, lactose non-fermenting organisms produce colorless colonies, allowing clear differentiation, particularly of Salmonella and Shigella species.
5. Applications in Microbiology:
5.1. Clinical Microbiology and Gut Microbiome Analysis:
Deoxycholate Agar (M030) is widely used in clinical microbiology laboratories for the examination of stool specimens to enable the isolation and presumptive identification of enteric pathogens, including Salmonella, Shigella, and other members of the family Enterobacteriaceae. Deoxycholic acid, a natural secondary bile acid produced in the human gastrointestinal tract, is incorporated into the medium, thereby mimicking a physiologically relevant component of the intestinal environment rather than functioning solely as an artificial selective agent.
The selective action of deoxycholate facilitates the recovery of pathogenic enteric bacteria from specimens containing a complex and dense gut microbiota, which is largely composed of commensal organisms. By inhibiting the growth of competing Gram-positive flora, the medium enhances the detection of clinically significant pathogens against the background of normal intestinal microbiota.
5.2. Food and Beverage Microbiology:
In food and beverage testing, Deoxycholate Agar is used to detect enteric bacterial contamination arising from raw materials, processing environments, or post-processing handling. Food matrices often harbor diverse microbial populations; the selective and differential nature of the medium enables targeted isolation of enteric pathogens from these complex microbial ecosystems, supporting food safety and quality assurance programs.
5.3. Water Quality and Environmental Microbiology:
Deoxycholate Agar is applied in water quality monitoring to assess fecal contamination and the potential presence of enteric pathogens in environmental water samples. Its ability to selectively recover bile-tolerant enteric bacteria makes it a valuable medium for evaluating microbial risks within environmental microbiomes.
5.4. Cosmetic Microbiology:
In cosmetic microbiological quality assurance, Deoxycholate Agar (M030) is utilized as a selective and differential culture medium for the detection and recovery of objectionable enteric microorganisms from raw materials and finished products. Its formulation, incorporating bile salt–mediated selective inhibition and lactose-based differentiation, facilitates the isolation of enteric bacteria present at low concentrations or in a metabolically compromised or sub lethally stressed state, thereby ensuring conformity with applicable regulatory and pharmacopoeia microbiological standards.
6. HiMedia Deoxycholate Agar M030:
HiMedia Laboratories Pvt. Ltd. manufactures Deoxycholate Agar (M030) as a high-quality, dehydrated selective and differential culture medium, produced under stringent quality management systems. HiMedia’s Deoxycholate Agar (M030) is formulated in alignment with internationally accepted microbiological specifications and is widely utilized in clinical diagnostics, industrial quality control, and microbiological research laboratories.
HiMedia Deoxycholate Agar (M030) is specifically designed for the selective isolation of enteric pathogens from fecal, food, and water samples, as well as for the presumptive differentiation of lactose-fermenting and non-lactose-fermenting Gram-negative bacteria. The medium is routinely employed in clinical and food industry quality control programs to support microbiological safety and regulatory compliance.
Each production batch of HiMedia Deoxycholate Agar (M030) is subjected to comprehensive quality control testing, including evaluation of physical characteristics, gel strength, pH conformity, and microbiological performance using appropriate reference strains. These assessments ensure consistent growth characteristics and reliable colony morphology, enabling clear differentiation between lactose fermenters and non-fermenters.
The dehydrated formulation of HiMedia Deoxycholate Agar (M030) offers excellent batch-to-batch reproducibility, ease of preparation, and extended shelf life. Its performance consistency and compatibility with standardized laboratory methodologies support adherence to international microbiological testing practices.
In order to address concerns related to BSE/TSE risks associated with animal-derived ingredients, HiMedia has developed Deoxycholate Agar, HiVeg® (MV030), in which animal-origin peptones are replaced with HiVeg® peptones and sodium deoxycholate is substituted with Synthetic Detergent No. III. The medium demonstrates performance characteristics equivalent to those of the conventional Deoxycholate Agar (M030).
7. Interpretation of Results in HiMedia Deoxycholate Agar M030:
On HiMedia Deoxycholate Agar M030, lactose-fermenting organisms such as Escherichia coli and Klebsiella spp. produce pink to red colonies, frequently associated with localized bile precipitation due to acid production.
In contrast, non-lactose-fermenting bacteria such as Salmonella spp. and Shigella spp. produce colorless or pale colonies on the medium. This clear difference in colony appearance makes it easier to recognize and pick suspected pathogens for further biochemical and serological testing.
8. Conclusion:
Deoxycholate Agar (M030) is a reliable selective and differential medium for isolating and differentiating enteric Gram-negative bacteria. Its combination of sodium deoxycholate and lactose enables effective suppression of competing flora and clear differentiation of lactose-fermenting and non-fermenting organisms. With standardized formulations such as HiMedia Deoxycholate Agar (M030), the medium ensures consistent performance, ease of result interpretation, and compliance with regulatory standards, making it an essential tool for microbiological analysis in clinical diagnostics, food safety, water quality monitoring, and related testing applications.
Acknowledgement: The authors express their sincere gratitude to Dr. Rahul Warke (Director, Microbiology Department) and Dr. Girish Mahajan (Senior Vice President, Microbiology Department) for their exceptional scientific guidance, critical insights, and continuous support throughout the development of this work. The authors also thank Ms. Vrutti Mistry (Scientific Writer) for her support in drafting the manuscript.
Reference:
- Leifson E. New culture media based on sodium desoxycholate for the isolation of intestinal pathogens and for the enumeration of colon bacilli in milk and water. The Journal of Pathology and Bacteriology. 1935;40(3):581-599. doi:https://doi.org/10.1002/path.1700400315
- HiMedia Laboratories. Deoxycholate Agar. Himedialabs.com. Published 2024. https://www.himedialabs.com/in/m030-deoxycholate-agar.html
- International Organization for Standardization. ISO 11133:2014(en) Microbiology of food, animal feed and water — Preparation, production, storage and performance testing of culture media. Iso.org. https://www.iso.org/obp/ui/en/#iso:std:iso:11133:ed-1:v2:en